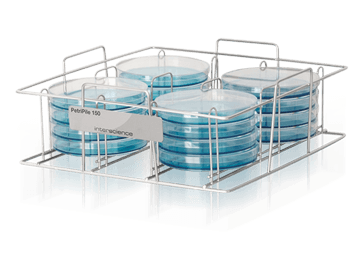

PetriPile®培養皿支架
PetriPile可確保安全拿起放下、運輸和儲存培養皿。
符合人體工學,讓培養箱的裝載更輕鬆,培養皿都能清楚看到。

人體工學
可堆疊,堅固耐用。PetriPile讓培養皿的儲存更有序。把培養皿放入培養箱也更簡單。符合人體工學的把手有利於運輸。

使用方便
前面的書寫區域可以標記批號,以便快速區分批次。培養皿間的空間保證了良好的通風。
| 適用於多種規格的培養皿 | |||
|
|
|
|
|
|
PetriPile 55 |
PetriPile 65 可放置36個Ø 65 毫米培养皿 |
PetriPile 90 可放置36個Ø 90 毫米培养皿 |
PetriPile 150 可放置16個Ø 150 毫米培养皿 |
| PetriPile 55 | PetriPile 65 | PetriPile 90 | PetriPile 150 | |
| 貨號 | 241 055 | 241 065 | 241 090 | 241 150 |
| 全不鏽鋼 | √ | √ | √ | √ |
| 可高壓滅菌 | √ | √ | √ | √ |
| 可疊加 | √ | √ | √ | √ |
| 培養皿直徑 | Ø 55 毫米 | Ø 65 毫米 | Ø 90 毫米 | Ø 150 毫米 |
| 培養皿數量 | 36個 | 16個 | ||
| 淨重 | 0.79 公斤 | 0.77 公斤 | 1.03 公斤 | 0.88 公斤 |
| 尺寸 (寬 x 深 x 高) | 21.5 x 27.2 x 13 公分 | 21.5 x 30.4 x 13 公分 | 26 x 37.6 x 13公分 | 35.6 x 37.8 x 13 公分 |
| 外箱尺寸 (寬 x 深 x 高) | 28.5 x 23 x 15 公分 | 31.5 x 23.5 x 14.5 公分 | 38 x 27.5 x 15 公分 | 39 x 37 x 14.5 公分 |
| 毛重 | 1.12 公斤 | 0.98 公斤 | 1.4 公斤 | 1.26 公斤 |